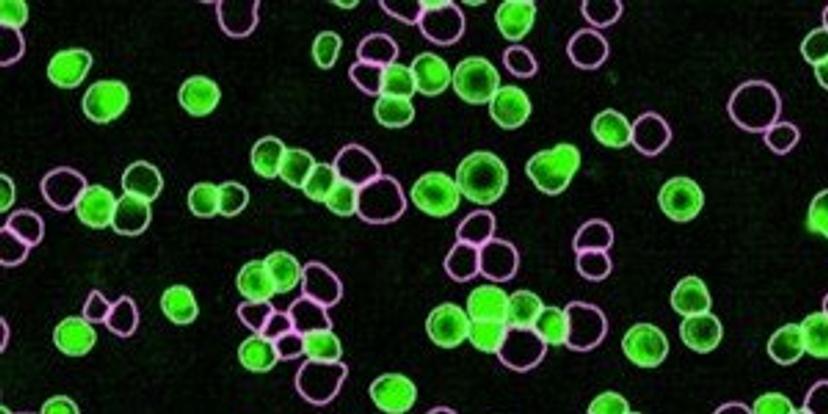

19 top new resources for cancer research
Exclusive interviews, new methods, free downloads and much more to help advance your cancer research
11 Jun 2020

Aiming to improve treatment options and patient outcomes is at the forefront of cancer research. New techniques and innovations designed to deepen our understanding of the mechanisms of cancer and how they may be targeted are emerging all the time. In this compilation of top new resources, we hear from leading scientists maximizing the information obtained from tiny patient biopsy samples to improve assay flexibility, find out how patient-derived organoids are becoming promising models for personalized treatment, take a look at the new technology enhancing phosphorylation detection from convenient TR-FRET assays, and explore how single-domain antibodies are advancing cancer research.

Organoid advances: How 3D tissue cultures are transforming personalized therapies
Find out how patient-derived organoids are becoming models for personalized treatment.

Immune cells: How live-cell analysis is supporting vital new therapeutics
Download this white paper from Sartorius to discover how enhanced data analytics and translational models can provide new biological insights.
Cellular analyses: Enhanced live-cell monitoring without removing samples from the incubator
In this white paper, Sartorius highlights its new cell-by-cell analysis module, an integrated solution that is designed to allow users to ‘count and classify’ heterogeneity in cell populations over time.

Reproducibility: New O2 and CO2/O2 multigas incubators ‘minimize uncertainty’
Discover the latest CO2 and CO2/O2 multigas laboratory incubators, designed to sustain accurate in vitro models of in vivo environments for optimum cell growth and reproducibility.

Cell models: Rapid drug screening accelerates research for personalized medicine
In this video, Dr. David Donner, Director of the Surgical Oncology Research Lab at the University of California, explains how he uses drug dispensing technology and patient-derived organoids to enable vital research into liver malignancies.

PROTACs: Accurately monitor PROTAC function in live cells
In this application note, BMG LABTECH demonstrates how the CLARIOstar with ACU can be used with NanoBRET™ technology, developed by Promega, to monitor PROTAC function in live cells.

Cryogenic samples: Transport biospecimens safely for over three hours
In this video, Brooks Life Sciences provides an overview of the features of the CryoPod™ Carrier, a safe, portable, and trackable solution for hand carrying temperature-sensitive biological materials.

Immunoassays: The robust ready-to-use assay for accurate phosphorylation detection
This application note demonstrates how using homogeneous TR-FRET based immunoassays for the detection of phosphorylated or total proteins in cell lysates can be a robust, rapid alternative when compared to conventional methods such as western blot, ELISA, or expensive bead-based assays.

Prevent relapse: The industry's only platform for single-cell multi-omics and DNA analysis
Find out how the Tapestri Platform from Mission Bio is empowering researchers and clinicians to predict and prevent cancer relapse, and ultimately, drive precision medicine forward.

Reveal more: Exploring B cell immunology with the latest technology in flow cytometry
In this video, Dr. Carol Schrader, Associate Professor at the University of Massachusetts Medical School, discusses her research on the processes involved in B cell immunology that lead to mutations and lymphoma.

Nanobodies: Using single-domain antibodies to advance cancer research
Learn how single domain antibodies enable scientists and engineers to advance cancer research, drug development, and therapy.
More exclusive interviews:
- Predicting patient response to immunotherapy treatment: Dr. Ofer Sharon discusses a new cancer research platform designed to improve patient outcomes, cut costs, and minimize unnecessary adverse events. Read article>>
- Examining infiltrating helper T cells: Automated cell counting saves time for immuno-oncology experiments: Learn how one immunology lab upgraded its cell counter to discriminate cells in a mixed population and streamline viability counts. Read article>>
- Next-generation bispecific antibodies clear circulating antigens while also targeting tumors: We interview Prof. Harald Kolmar, TU Darmstadt, about an exciting new approach in cancer therapy. Read article>>
- Harnessing next-generation cell culture methods in the fight against cancer: Learn how an institute in the US is developing the latest patient-derived 3D cancer cell cultures for use in precision medicine. Read article>>
Other resources in cancer research:
- Developing solid tumor and hematological panels for a flexible and automated microfluidic workflow: In this study, Fluidigm designed two amplicon-based, targeted NGS library preparation (LP) panels for detecting single-nucleotide variants, insertions and deletions, copy number variants, and RNA fusions. Download method>>
- Developing next-generation therapeutic antibodies: This application note covers next-generation antibodies and the challenges associated with traditional technologies for antibody-based discovery and development. Download method>>
- IHC antibodies you can rely on: Here, PROGEN outlines its comprehensive portfolio of IHC antibodies, featuring a unique selection of markers for many pathologies, organs, and tissues. Download method>>
- 3D analysis of co-culture cancer spheroids: In this case study, confocal images of co-culture spheroids are quantitatively analyzed using NoviSight™ software to evaluate their cell population and determine drug sensitivity in each cell. Download method>>
Your recommendations:
Take a look at what other researchers and scientists all over the world are saying about the latest equipment and technologies in cancer research. Antonio Barbachano, from CIBERONC-IIB, shared his opinion on the Corning Matrigel Matrix for Organoids by Corning Life Sciences:
